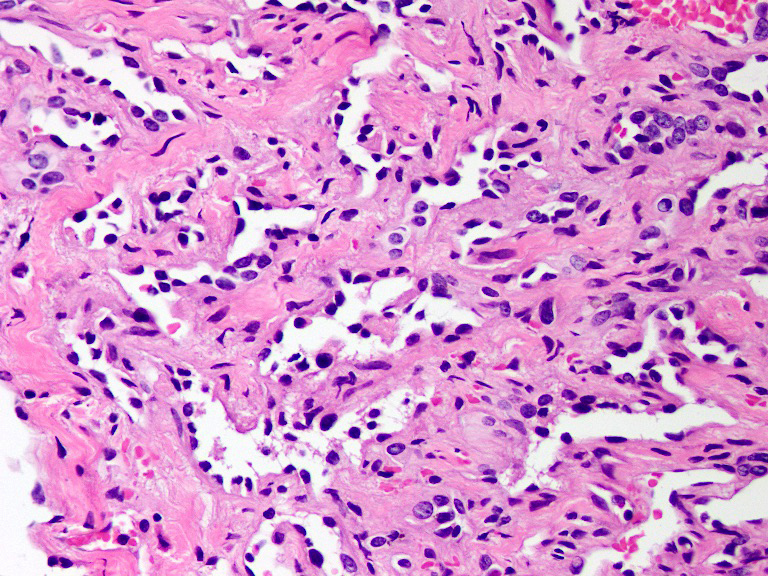

Table of Contents
Definition / general | Essential features | Terminology | ICD coding | Epidemiology | Sites | Pathophysiology | Etiology | Clinical features | Diagnosis | Laboratory | Radiology description | Radiology images | Prognostic factors | Case reports | Treatment | Clinical images | Gross description | Gross images | Microscopic (histologic) description | Microscopic (histologic) images | Cytology description | Positive stains | Negative stains | Molecular / cytogenetics description | Molecular / cytogenetics images | Videos | Sample pathology report | Differential diagnosis | Additional references | Practice question #1 | Practice answer #1 | Practice question #2 | Practice answer #2Cite this page: Chundriger Q, Nusrat A, Ud Din N. Retiform hemangioendothelioma. PathologyOutlines.com website. https://www.pathologyoutlines.com/topic/softtissuehemangioendotheliomaretiform.html. Accessed August 27th, 2025.
Definition / general
- Vascular neoplasm with locally aggressive behavior and characteristic morphology among other vascular lesions; exhibits a high recurrence rate and rarely has metastatic potential
Essential features
- Locally aggressive, infiltrating vascular neoplasm composed of elongated arborizing vascular channels lined by endothelial cells with prominent hobnail nuclei with hyperchromasia but no atypia and rare mitotic activity
- Presents as plaque-like areas of discoloration and high rate of local recurrence after incomplete excision
Terminology
- Hobnail hemangioendothelioma (also used for papillary intralymphatic angioendothelioma / Dabska tumor)
ICD coding
- ICD-O: 9136/1 - retiform hemangioendothelioma
- ICD-11: 2B56.1 & XH64U8 - angiosarcoma of skin & retiform hemangioendothelioma
Epidemiology
- Young adults > children (Indian J Dermatol 2014;59:633)
- M = F (Indian J Pathol Microbiol 2020;63:122)
- Previously considered to be more common in women (J Cutan Aesthet Surg 2022;15:319)
Sites
- Common
- Distal extremities: 50% (J Med Case Rep 2021;15:69)
- Less common
- Trunk
- Genitalia
- Head and neck
- Grows within and replaces the dermis with variable involvement of subcutis (Hornick: Practical Soft Tissue Pathology - A Diagnostic Approach, 2nd Edition, 2018)
Pathophysiology
- Not known
Etiology
- Not known
- Case reports of lesions arising after low dose radiation and in association with lymphedema (Milroy disease)
Clinical features
- Plaque-like, red to blue areas of discoloration
- Size range: 3 - 12 cm
Diagnosis
- Diagnosis is usually made on morphology alone
- Immunohistochemical markers help confirm the vascular nature of the lesion
Laboratory
- Not significant
- Single case report of increased CA19-9 levels in a patient with splenic retiform hemangioendothelioma and concomitant hepatic amyloidosis (World J Clin Cases 2020;8:1108)
Radiology description
- CT scan and MRI: solid enhancing mass lesion
- Digital subtraction angiography (DSA): helps to identify feeding vessels for embolization
Radiology images
Prognostic factors
- Recurrence rates up to 60%
- Margin involvement predisposes to recurrence
Case reports
- 9 year old girl with medial canthus of eye lesion (Indian J Ophthalmol 2014;62:491)
- 30 year old woman with dry cough, dyspnea and pleural effusion (Diagn Pathol 2015;10:194)
- 63 year old woman with longstanding nodule on vulva (J Int Med Res 2021;49:3000605211027783)
Treatment
- Treatment of choice: complete excision with clear margins
- Mohs micrographic surgery (J Am Acad Dermatol 2011;65:233)
- Chemoradiation for locally aggressive lesions (J Cancer Res Ther 2015;11:657, Indian J Otolaryngol Head Neck Surg 2006;58:196)
- Low dose cytotoxic drugs (cisplatin) (Sarcoma 2010;2010:756246)
Clinical images
Gross description
- Grossly resected specimen may appear hyperemic or erythematous / hemorrhagic
- Cut surface is gray, white-gray, brown (Case Rep Otolaryngol 2014;2014:715035)
Microscopic (histologic) description
- Poorly circumscribed lesion, infiltrating dermis and subcutis with dissecting planes (Int J Clin Exp Pathol 2010;3:528)
- Composed of elongated arborizing vascular channels that resemble rete testis, hence the name
- Endothelial cells are bland with hobnailed hyperchromatic nuclei
- Nuclear atypia is not seen
- Mitotic figures are rare
- Lesional stroma is fibrotic and shows lymphoid infiltrate (J Med Case Rep 2021;15:69, Int J Clin Exp Pathol 2010;3:528)
- Occasional solid growth may be seen (Stockman: Diagnostic Pathology - Vascular, 1st Edition, 2015)
- In the dermis, vessels may become ectatic and lose retiform appearance
- Occasional cells with cytoplasmic lumina may be rarely seen (J Med Case Rep 2021;15:69)
- Occasionally, intraluminal papillary proliferation may be seen, resembling Dabska tumor (Hornick: Practical Soft Tissue Pathology - A Diagnostic Approach, 2nd Edition, 2018)
- May arise as a retiform component in a composite hemangioendothelioma (Surg Case Rep 2021;7:249)
- Lacks adjacent areas resembling lymphangioma, seen in other types of hemangioendothelioma, such as Dabska tumor (Weiss: Enzinger and Weiss's Soft Tissue Tumors, 7th Edition, 2019)
Microscopic (histologic) images
Cytology description
- Aspiration yields only hemorrhage (Case Rep Otolaryngol 2014;2014:715035)
Positive stains
- CD31: membranous staining
- CD34: membranous staining
- ERG: nuclear staining
- Claudin5: cytoplasmic staining (Am J Surg Pathol 2011;35:1848)
- VEGFR2: membranous staining (Am J Surg Pathol 2012;36:629)
- PROX1: nuclear staining (Am J Surg Pathol 2012;36:351)
Negative stains
- D2-40 (podoplanin): single study reports > 80% of retiform hemangioendothelioma cases to be positive for D2-40, while most of the literature reports it to be negative (Am J Surg Pathol 2012;36:351)
- HHV8
- VEGFR3
Molecular / cytogenetics description
- 38% of cases in a single study were shown to harbor YAP1 gene rearrangements, with a subset showing YAP1::MAML2 fusions (Am J Surg Pathol 2020;44:1677)
Videos
Hemangioendotheliomas
Pathology of hemangioendotheliomas
Sample pathology report
- Thigh lesion, shave excisional biopsy:
- Vascular neoplasm with locally aggressive course, consistent with retiform hemangioendothelioma (see comment)
- Comment: These tumors are known to recur (recurrence rate up to 60% in the literature), particularly when resection margins are not clear.
Differential diagnosis
- Hobnail hemangioma:
- Well circumscribed cutaneous lesion
- Superficial vessels are more hobnail as compared to deep ones
- No local recurrence reported
- Papillary intralymphatic angioendothelioma (PILA / Dabska tumor):
- Intraluminal papillary formations are diffusely present with perivascular and papillary core hyalinization
- Similar areas may be seen in some examples of retiform hemangioendothelioma but this entity lacks typical retiform architecture
- D2-40 positivity in endothelial cells
- Adjacent lymphangioma-like areas and hemosiderin deposition may be seen
- Composite hemangioendothelioma:
- Shows mixture of more than hemangioendothelioma types, including Dabska tumor, retiform hemangioendothelioma and hobnail hemangioendothelioma, etc. in various combinations
- Whenever possible, thorough sampling should be done to exclude a possibility of composite hemangioendothelioma when any hemangioendothelioma pattern is encountered
- Kaposi sarcoma:
- Mostly arises in HIV patients with typical clinical presentation
- Composed of slit-like vessels with spindle cells, hyaline globules and appreciable mitotic activity
- Immunohistochemistry for HHV8 is positive
- Angiosarcoma:
- Ill defined lesion with infiltrative appearance, mostly in older patients
- Shows various architectural patterns with well formed vascular spaces, spindle cells with extravasated red blood cells, all showing prominent nuclear atypia and brisk mitotic activity
- Atypical vascular lesion:
- Develops in skin a few years after radiation
- Mostly confined to dermis
- Interconnected vascular channels lined by flattened to hobnail cells
- May resemble retiform hemangioendothelioma in small biopsies; clinical history is important in distinguishing the two
Additional references
Practice question #1
A 30 year old man presents with a red to purple plaque involving the right thigh. A punch biopsy through the lesion shows light microscopic features as depicted in the photomicrograph above. Which of the following is the most likely diagnosis in this case?
- Atypical vascular lesion
- Intramuscular angioma
- Kaposi sarcoma
- Papillary intralymphatic angioendothelioma
- Retiform hemangioendothelioma
Practice answer #1
E. Retiform hemangioendothelioma. The photomicrograph shows a vascular lesion with retiform vessels lined by a single layer of endothelial cells with hobnailing. A lymphoid aggregate is also present. Answers B - D are incorrect because other characteristic essential features of any of the given options, except atypical vascular lesion, are not seen here. Answer A is incorrect because the clinical scenario is not appropriate for a diagnosis of atypical vascular lesion. Therefore, the correct diagnosis is retiform hemangioendothelioma.
Comment Here
Reference: Retiform hemangioendothelioma
Comment Here
Reference: Retiform hemangioendothelioma
Practice question #2
A 45 year old HIV positive woman presents with a violaceous papule on her neck. Punch biopsy of the lesion shows crushing artifacts. Preserved areas show interconnected rete testis-like vascular spaces lined by a single layer of endothelial cells with hobnailing. Which of the following is the most important immunohistochemical stain to differentiate the diagnosis from other possibilities in the scenario?
- CD34
- Claudin5
- D2-40
- HHV8
- Ki67
Practice answer #2
D. HHV8. In the given clinical scenario, the most important differential diagnostic consideration here is Kaposi sarcoma. HHV8 is known to be positive in Kaposi sarcoma but not in retiform hemangioendothelioma, which is the correct diagnosis. Answers A and B are incorrect because CD34 and claudin5 are positive in both retiform hemangioendothelioma and Kaposi sarcoma. Answer C is incorrect because D2-40 can be positive in some cases of both. Answer E is incorrect because Ki67 or MIB1 proliferative index is not a diagnostic marker for either diagnosis.
Comment Here
Reference: Retiform hemangioendothelioma
Comment Here
Reference: Retiform hemangioendothelioma